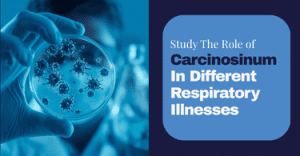

-
Dr Dixita Pirojiya
MD Part II
C.D. Pachchigar Homoeopathic college &Hospital
Homoeopathic Materia Medica
Posts
Study The Role of Carcinosinum In Different Respiratory Illnesses
Abstract Respiratory illnesses such as bronchial asthma, allergic rhinitis, chronic bronchitis, and chronic obstructive pulmonary disease (COPD) are common chronic conditions that significantly affect the...

